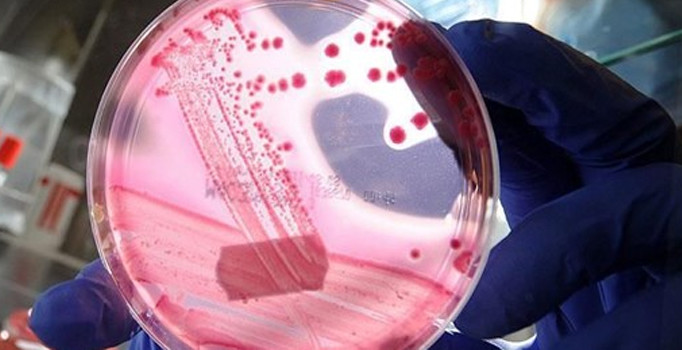
Her 3 kanser vakasından ikisini önlemek mümkün

Nutrigenetik ve Kişiye Özel Tıp Derneği Başkanı Dr. Serdar Savaş, genlerden yola çıkılarak hazırlanan koruyucu tıp uygulamalarıyla her üç kanser vakasından ikisinin önlenebileceğini belirterek, "Kardiyovasküler hastalıklardan sonra ikinci en sık ölüm sebebi olan kanserler, genetik, yaşam tarzı ve çevresel faktörlerin bir araya gelmesiyle oluşuyor. Kanserlerde genetik yatkınlık, sorun ortaya çıkmadan bilinirse, başta beslenme olmak üzere yaşam tarzı düzenlemeleriyle hastalığın ortaya çıkması tamamen engellenebilir veya geciktirilebilir" dedi.
Savaş, "Dünya Kanser Günü" dolayısıyla yaptığı açıklamada, 21. yüzyılda ölümlerin başlıca nedeni olan kronik ve kompleks hastalıkların başında kalp hastalıkları, kanserler, diyabet, osteoporoz, alzaymır ve beyin-damar hastalıklarının geldiğini söyledi.
Tıp dünyasının, daha önceki yıllarda sadece çevresel faktörlerin neden olduğu hastalıklara müdahale edilebildiğini ancak günümüz teknolojisinde genetik yatkınlıkların ve yaşam faktörlerinin birleşmesiyle ortaya çıkan kanser gibi rahatsızlıklara karşı erken tedbir alınabildiğini aktaran Savaş, Türkiye'de ölümlerin ikinci büyük nedeni olan kanserlerden genlere uygun yaşayarak korunmanın mümkün olduğunu vurguladı.
Dr. Serdar Savaş, "Genlerden yola çıkılarak hazırlanan koruyucu tıp uygulamalarıyla her üç kanser vakasından ikisi önlenebilir. Kardiyovasküler hastalıklardan sonra ikinci en sık ölüm sebebi olan kanserler, genetik, yaşam tarzı ve çevresel faktörlerin bir araya gelmesiyle oluşuyor. Kanserlerde genetik yatkınlık, sorun ortaya çıkmadan bilinirse, başta beslenme olmak üzere yaşam tarzı düzenlemeleriyle hastalığın ortaya çıkması tamamen engellenebilir veya geciktirilebilir" ifadelerini kullandı.
Savaş, 2030'a kadar kanserin görülme sıklığında tüm dünyada iki misline yakın bir artış öngörüldüğüne işaret ederek, şunları kaydetti:
"Bu bağlamda kanserle mücadele için koruyucu ve önleyici hekimliğin yayılması gerekiyor. Birçok kanser türünden basit yöntemlerle korunmak mümkündür. Asıl mesele kimin, hangi önlemi alması gerektiğidir. Birçok insan sigara içer, bazıları kanser olur. Kimi insan günde iki paket sigara içer fakat kanser olmaz. Bunun nedeni bireyin akciğer kanserine olan genetik yatkınlığıdır. En sık görülen meme, prostat, kalın bağırsak, mide ve cilt kanserlerinde de aynı durum geçerlidir. Bu kanser türlerinden genetik yatkınlığımıza göre farklı önlemler alarak korunabiliriz"
"SİSTEMLE BİREYİN GENETİM YAPISI ANALİZ EDİLİYOR"
Nutrigenetik ve Kişiye Özel Tıp Derneği Başkanı Dr. Savaş, elbette sigara içmemek gibi genel bir önerinin herkes için geçerli olduğunu ancak oksidatif stres, yetersiz detoks, DNA kırıklarının tamir edilememesi gibi kişiden kişiye farklılık gösteren yatkınlıkların da kontrol altına alınması gerektiğini söyledi.
Dr. Savaş, bunu gentest uygulamalarıyla hayata geçirebildiklerini aktararak, "Bu modelde, bireyin genetik yapısını analiz ederek hücresel düzeyde vücudunun nasıl çalıştığını anlıyoruz. Hücresel işlevlerde tespit ettiğimiz aksaklıkların ne tür hastalıklara yol açacağını ortaya koyuyoruz" şeklinde konuştu.
Bunlara genetik yatkınlık denildiğini vurgulayan Savaş, konuşmasını şöyle sürdürdü:
"Genetik yatkınlıklar tek başlarına hastalığa neden olmaz. Bu yatkınlıklara bireyin yaşam tarzıyla çevresel faktörlerin eklenmesi hastalığı ortaya çıkarır. Bu nedenle kişinin başta beslenmesi olmak üzere besin destekleri kullanımını, fizik aktivitesini, uykusunu, gerektiğinde stres düzeyini analiz ediyoruz. Ayrıca biyokimyasal, hormonal analizlerini hatta kandaki aminoasit düzeylerini inceliyoruz. Böylece o bireyin hiçbir yerde olmayan binlerce verisini elde ediyoruz. Buna bir çeşit 'Big Data analizi' de diyebiliriz. Tüm bu analizler epidemiyolojik ve istatistiki yöntemler kullanılarak bilgiye dönüştürülüyor. Günümüzde bu süreci tanımlayan bilim 'biyoenformatiktir'. Sonuçta, bireyde hiçbir belirtisi olmasa dahi, kalp krizi, kanserler, diyabet gibi ölümcül hastalıkların risklerini ve alzaymır gibi yaşam kalitesini bozan hastalıklara yatkınlıkları ortaya koyuyoruz"
"AVRUPA'DAKİ EN İYİ UYGULAMAYIZ"
Dr. Serdar Savaş, bu konuda dünyada da çeşitli ülkelerde uygulamalar olduğunu dile getirerek, "Ancak övünerek söyleyebilirim ki biz Avrupa'daki en iyi uygulamayız. Bunu biz değil, Avrupa Birliği Toplum Sağlığı Genom-Bilim Programı söylüyor" dedi.
Bundan 15-20 yıl sonra gentest modelinin tüm Avrupa'da uygulanmaya başlanacağını vurgulayan Savaş, sözlerini şöyle tamamladı:
"Bu çalışma yapılırken kişiden kişiye farklılık gösterecek önlemler alınmalıdır. Bireyin kansere yol açan genetik yatkınlıkları tespit edilerek bunlar doğrultusunda kişiye özel uygun yaşam tarzı planı geliştirilir ve sürdürülürse, her üç kanser vakasından ikisi önlenebilir. Tıp biliminde sessiz bir devrim başlatan koruyucu genetik çalışmaları neticesinde sadece kanserler değil, kalp krizi, inme, diyabet, obezite, alzaymır ve kemik erimesi gibi pek çok kompleks hastalıktan korunmak mümkün"